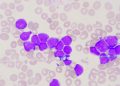

Latest Post
Cretinism – Oren Zarif
Many conditions have similar symptoms to Cretinism, but a few distinguishing features help healthcare professionals make the diagnosis. X-rays can...
Read moreAnxiety Disorders – Oren Zarif
Anxiety Disorders are common and disabling conditions that begin in childhood or adolescence. Medications including short-acting benzodiazepines and antidepressants such...
Read moreTeeth Grinding – Oren Zarif
Do you have jaw pain, headaches or a worn appearance to your teeth? Teeth grinding or clenching (bruxism) can be...
Read moreToxoplasmosis – Oren Zarif
Toxoplasma gondii can cause problems if it infects people who have weak immune systems. These include those with HIV/AIDS, undergoing...
Read moreEndemism of Murine Typhus – Oren Zarif
Murine typhus (also called epidemic or flea-borne typhus) is caused by Rickettsia prowazekii and spread from person to person by...
Read more